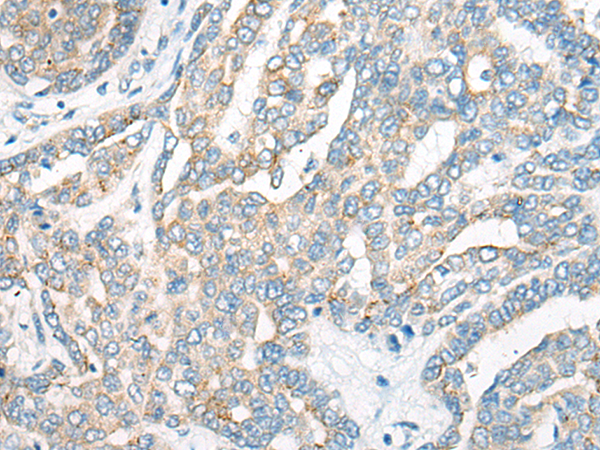

|
Background: |
Second messenger, cAMP, causes the opening of cation-selective cyclic nucleotide-gated (CNG) channels and depolarization of the neuron (olfactory sensory neurons, OSNs). CNGA4 is the modulatory subunit of this channel which is known to play a central role in the transduction of odorant signals and subsequent adaptation. By accelerating the calcium-mediated negative feedback in olfactory signaling it allows rapid adaptation to odor stimulation and extends its range of odor detection. |
|
Applications: |
ELISA, WB, IHC |
|
Name of antibody: |
CNGA4 |
|
Immunogen: |
Synthetic peptide of human CNGA4 |
|
Full name: |
cyclic nucleotide gated channel alpha 4 |
|
Synonyms: |
CNG4; CNG5; CNCA2; CNG-4; CNGB2; OCNC2; OCNCb; OCNCBETA |
|
SwissProt: |
Q8IV77 |
|
ELISA Recommended dilution: |
1000-2000 |
|
IHC positive control: |
Human thyroid cancer; Human brain |
|
IHC Recommend dilution: |
20-100 |
|
WB Predicted band size: |
66 kDa |
|
WB Positive control: |
Human cerebella tissue and Human cerebrum tissue lysates |
|
WB Recommended dilution: |
200-1000 |
購(gòu)物車(chē)
幫助
021-54845833/15800441009
